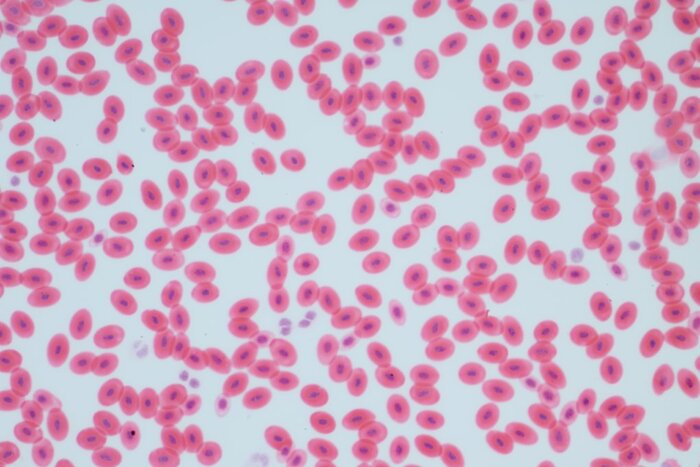

Кровь человека под микроскопом
Кровь - одна из самых важней тканей в организме человека. Состоит из плазмы (жидкости) и форменных элементов (клеток).
Разделяют три основных типа форменных элементов:
1) Эритроциты (красные кровяные тельца), которые ответственные за перенос кислорода и удаление углекислого газа из организма;
2) Тромбоциты (кровяные пластинки), они защищают и ремонтируют поврежденные сосуды, с помощью образования тромбов;
3) Лейкоциты (белые клетки крови), ответственные за защиту организма и иммунитет.
На картинке вы можете посмотреть как рисунки, так и настоящую микрофотографию форменных элементов крови.
Обратите внимание на отсутствие ядра у красных клеток (эритроцитов). Оно вытесняется в процессе формирования клетки для того, чтобы она могла лучше выполнять свои функцию (вмещала больше кислорода). Однако из-за этого срок жизни эритроцита составляет всего несколько месяцев (~120 дней).
Кстати у лягушки и других земноводных эритроциты по прежнему остаются ядерными клетками. И они намного крупнее по размеру, чем у человека.
Кровь лягушки под микроскопом
Соц.сети:
Дзен: https://dzen.ru/mysli_biologa
ВКонтакте: https://vk.com/mysli_biologa